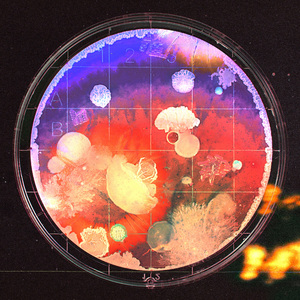
誰誰誰

谁谁谁
何炅

谁谁谁 (DJ版)
熊雨珂

谁谁谁 (抖音DJ原声版)
苏子琦

谁、谁、谁
崔健

谁谁谁
白静晨

谁谁谁
小苹果

谁谁谁
汪星宇

谁谁谁
拜尔

誰誰誰
アイナ・ジ・エンド
誰誰誰
アイナ・ジ・エンド

谁谁谁 (新版)
DJ榜单

谁谁谁
小漭娃儿常松

请和我恋爱
王彬

誰誰誰
アイナ・ジ・エンド

谁谁谁
喷嘭乐团

谁谁谁
音跃层Music

Bye Bye My Lover
王彬

谁谁谁
粉爱听

谁谁谁
CK

不想喜欢你(男声版)
王彬

睡在云上
王彬

谁的心已残缺
王彬

谁谁谁
DJ梦菲

谁谁谁
杨灿灿

输掉的年华
王彬

输掉的年华
王彬

谁谁谁(Cover 李易峰)
石不易

谁谁谁
夜屠灵, 赤羽

谁谁谁 (BGM版)
DJ榜单

谁谁谁
王政灵